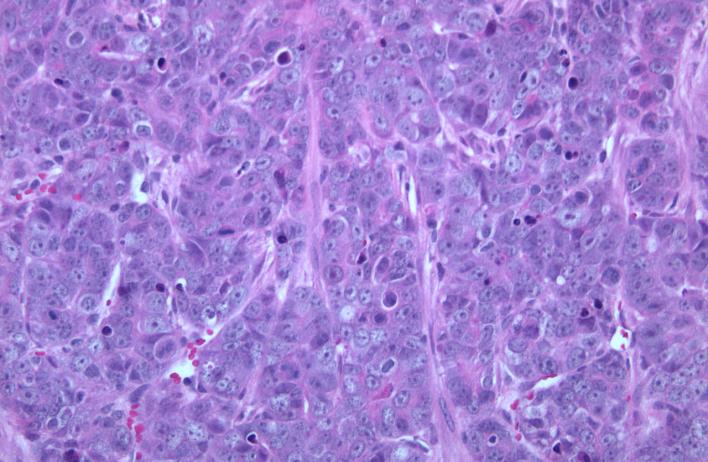
H&amp;E staining of a TP53-null mammary tumor
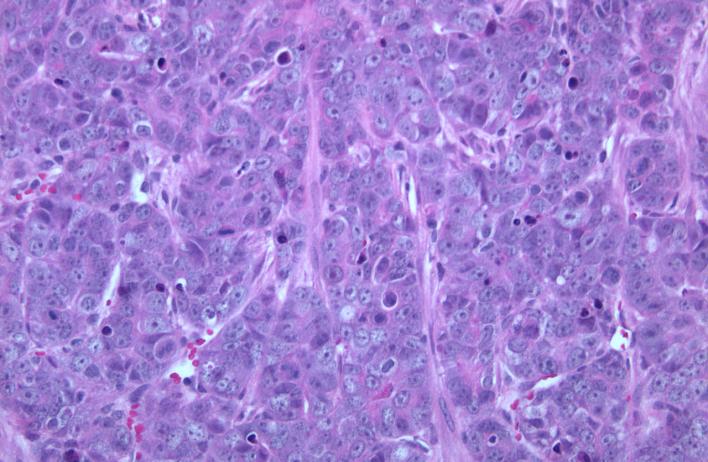

Although a hyperactive Wnt state exists in colon and other cancers as a consequence of genetic mutations in APC, the involvement of Wnt signaling in breast cancer is less understood. We have an active interest in how canonical and alternative Wnt signaling regulate tumor cell composition and diversity within breast cancer, along with how Wnt signals dictate adhesive and migratory states among cancer cells within the tumor ecosystem. We are interested the social cell biology surrounding breast cancer progression, with a particular emphasis on Wnt signaling mechanisms driving intercellular interactions among tumor cells, ultimately responsible for breast cancer progression and metastasis.